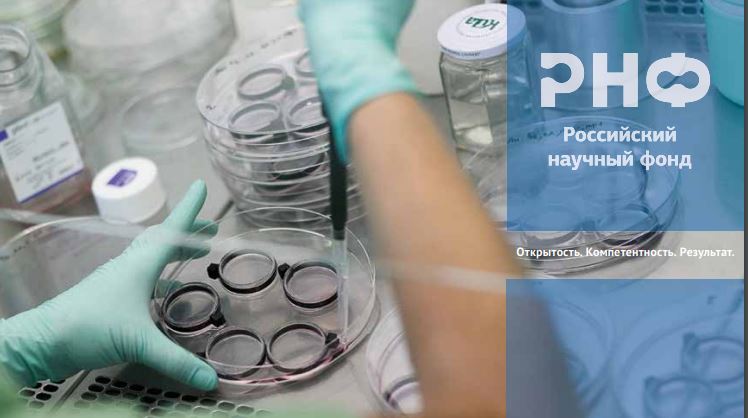
РНФ

Подведены итоги конкурсов Президентской программы исследовательских проектов 2023 года на получение грантов по мероприятиям «Проведение инициативных исследований молодыми учеными» и «Проведение исследований научными группами под руководством молодых ученых», а также конкурса на продление проектов научных групп под руководством молодых ученых, поддержанных в 2020 году.
Конкурс инициативных проектов направлен на поддержку молодых исследователей в возрасте до 33 лет, защитивших кандидатские диссертации, независимо от должности и гражданства. Согласно правилам конкурса, желающим переехать для реализации своего проекта в другой регион сумма гранта увеличивалась с 1,5 млн до 2 млн рублей.
Среди проектов по мероприятию «Проведение инициативных исследований молодыми учеными» победителем стала работа «Изучение роли обмена железа в патогенезе, прогрессировании и прогнозе редких вариантов легочной гипертензии». Ее представила доцент кафедры лабораторной медицины и генетики Института медицинского образования Центра Алмазова, к.м.н. Юлия Исмаиловна Жиленкова.
По мероприятию «Проведение исследований научными группами под руководством молодых ученых» автором одной из выигравших работ стал доцент кафедры патологии Института медицинского образования Центра Алмазова, к.м.н. Андрей Александрович Карпов с проектом «Механизмы фиброзного ремоделирования сосудов малого круга кровообращения при различных формах легочной гипертензии и поиск новых терапевтических воздействий».
Конкурс молодежных научных групп связан с поддержкой нового поколения научных лидеров. Фонд выделяет гранты для молодых кандидатов и докторов наук в возрасте до 35 лет. Размер одного гранта — от 3 до 6 млн рублей ежегодно, его продолжительность — 3 года с возможностью продления на конкурсной основе еще на 2 года. Реализация проекта должна быть направлена, в том числе, на развитие научной карьеры молодых ученых, расширение горизонтов планирования их научной работы, формирование исследовательских команд, которые в будущем смогут стать основой новых научных отделов, лабораторий.
Президентская программа исследовательских проектов была разработана Фондом в 2017 году. Ее основные задачи — поддержать долгосрочные проекты ведущих ученых и создать карьерные траектории для перспективных молодых исследователей.